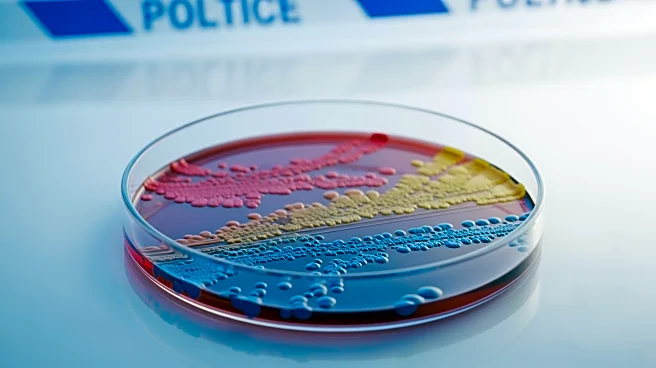
Microbiome's Role in Peanut Allergy Severity Explored by Researchers

What's Happening?
Researchers from the Autonomous University of Madrid and McMaster University have discovered that certain bacteria in the human mouth and gut can neutralize proteins that trigger severe allergic reactions to peanuts. The study identified two microbes,
Rothia and Staphylococcus, which naturally occur in human saliva and the small intestine, as capable of breaking down allergenic peanut proteins. This discovery was made through clinical studies involving children with peanut allergies, where those with higher levels of these bacteria showed a greater tolerance to peanut exposure. The findings suggest that these microbes could play a crucial role in managing peanut allergies by reducing the severity of allergic reactions.
Why It's Important?
This research holds significant implications for the management of peanut allergies, which affect a substantial portion of the population, particularly children. Peanut allergies can lead to life-threatening anaphylactic reactions, making them a major public health concern. The ability to mitigate these reactions through microbial intervention could revolutionize allergy treatment, offering a safer alternative to current methods like oral immunotherapy, which carries risks for those with severe allergies. By harnessing the natural capabilities of these microbes, there is potential to develop new probiotic treatments that could improve the quality of life for individuals with peanut allergies.
What's Next?
Further clinical testing is necessary to determine the safety and efficacy of using probiotics as a treatment for peanut allergies. Researchers aim to explore the potential of these microbes in reducing the severity of allergic reactions and to identify which patients might benefit most from such treatments. The study's findings could lead to the development of new therapeutic strategies that leverage the human microbiome to manage food allergies more effectively.
Beyond the Headlines
The study highlights the broader role of the human microbiota in influencing immune responses and managing allergic reactions. This research could pave the way for a deeper understanding of how microbial communities in the body interact with allergens and the immune system. It also underscores the potential of microbiome-based therapies in treating various immune-related conditions, offering a new frontier in personalized medicine.